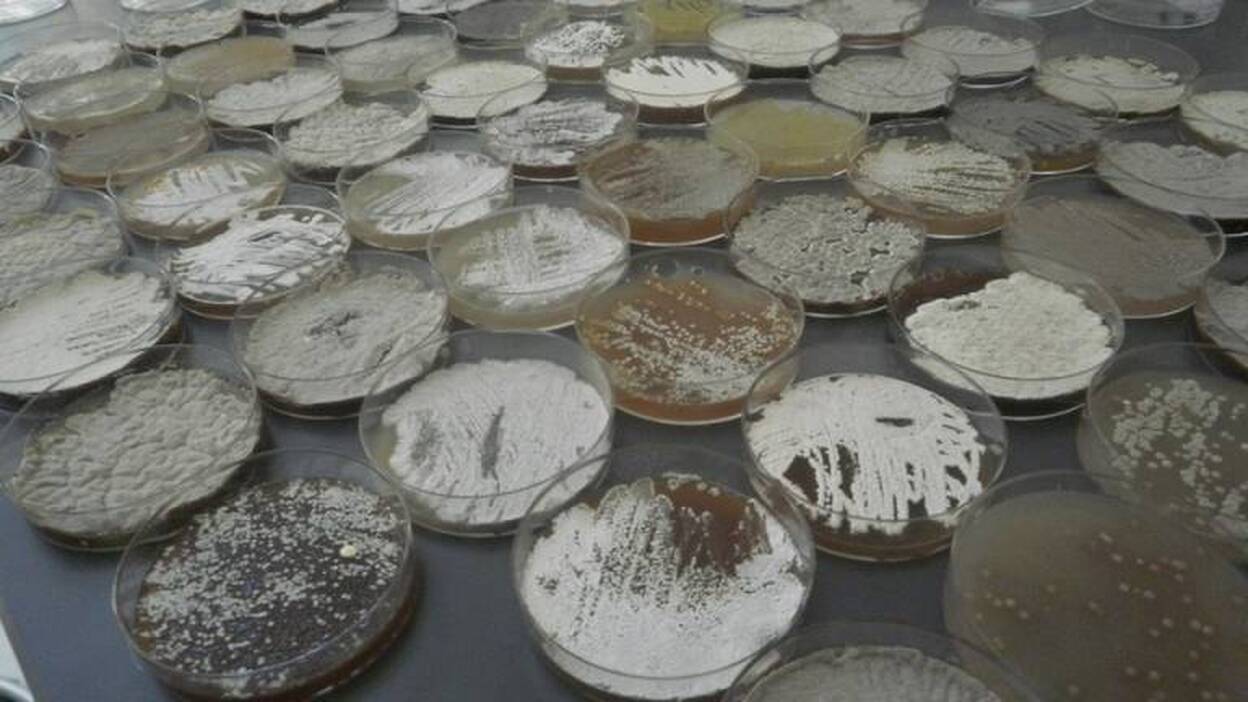
Científicos de Harvard muestran la resistencia de bacterias a antibióticos

Científicos de Harvard muestran la resistencia de bacterias a antibióticos
EFE
Viernes, 9 de septiembre 2016, 12:43
Científicos de la Universidad de Harvard (EEUU) presentaron un modelo con el que se observa la resistencia de las bacterias a los antibióticos diseñados para detenerlas o eliminarlas. Para su experimento, publicado en la revista Science, los investigadores crearon una placa de Petri rectangular de cuatro pies (122 centímetros) de largo y dos pies (61 centímetros) de ancho con nueve compartimentos horizontales. En los compartimentos de los dos extremos, los científicos de Harvard no introdujeron medicamento alguno, mientras que en los inmediatamente colindantes pusieron una dosis de trimetoprima, en los siguientes una cantidad 10 veces mayor de ese antibiótico, en los otros 100 veces y en el central 1.000 veces mayor a la primera. Los científicos introdujeron entonces unas dosis de la bacteria Escherichia coli, también conocida como E. coli en los extremos y durante los siguientes diez días comprobaron como fue avanzando hasta llegar al compartimento central y mutar en superbacteria. En sus conclusiones, los científicos mostraron como las primeras bacterias con baja resistencia a los antibióticos "dieron lugar a mutantes de resistencia moderada que finalmente generaron cepas altamente resistentes y capaces de defenderse de las más altas dosis de antibióticos". "A cada nivel de concentración, un pequeño grupo se adaptaba y sobrevivía", añadió el estudio, al constatar que las descendientes de las bacterias mutantes "migraban a las zonas de mayor concentración del antibiótico". Lo que permitió la placa de Petri fue "reconocer conceptos con los que se pensaba en abstracto", apuntó la investigadora Tami Lieberman, que participó en el experimento que calificó como "una demostración impresionante de la rapidez con la que evolucionan las bacterias".